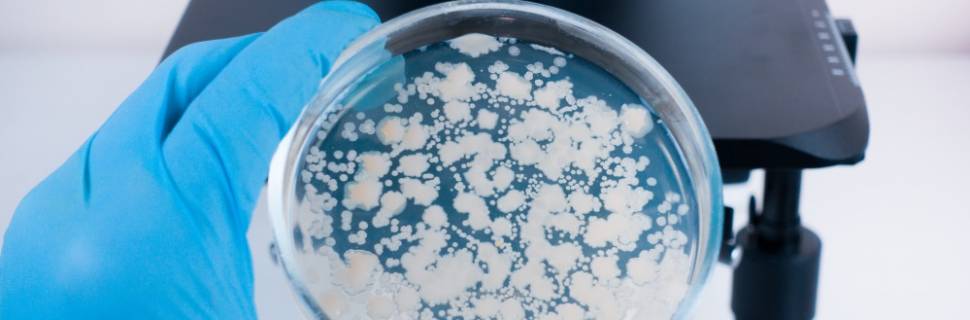
Saiba mais sobre as principais análises laboratoriais em pescado

Saiba mais sobre as principais análises laboratoriais em pescado
Márcia Cioffi, gerente do Laboratório TUV SUD SFDK explica sobre as principais análises e processos
12 de julho de 2021
Com foco na proteção do consumidor, a realização das análises laboratoriais em produtos alimentícios é um processo importante e indispensável para a segurança de alimentos. No pescado, essas análises possibilitam a verificação da conformidade dos produtos em relação aos aspectos de inocuidade, identidade e qualidade.
Entre as análises mais importantes para o pescado, estão as previstas nos regulamentos Ministério da Agricultura, Pecuária e Abastecimento (Mapa) e também da ANVISA. “Considerando os programas do Mapa destacam-se: PAC POA Nacional, PAC POA Importados e o Programa de Controle de Patógenos Oficial de Listeria monocytogenes em produtos de origem animal prontos para consumo ´ready to eat", explica Márcia Cioffi, gerente do Laboratório TUV SUD SFDK.
O PACPOA Nacional inclui a coleta de amostras de produtos de origem animal comestíveis fabricados em estabelecimentos sob SIF. Já no PACPOA Importados, a coleta das amostras oficiais é realizada por servidores do VIGIAGRO e o plano de amostragem é desenvolvido pelo DIPOA/SDA observando o volume de importação de produtos de origem animal pelo Brasil, produtos e países de origem que apresentaram maior número de não conformidades detectadas durante os procedimentos de reinspeção realizados nos anos anteriores.
“Observamos nos últimos anos que as coletas do VIGIAGRO vêm tendo foco nos peixes congelados, peixe em conserva e também os peixe salgados”, falou a gerente.
Conforme ela, os parâmetros físico-químicos e microbiológicos analisados nas amostras coletadas para atendimento ao PACPOA estão definidos em atos normativos. Entre alguns exemplos, temos:; Relação Unidade/Proteína, Sódio, Umidade, pH, Bases Voláteis, Histamina, Salmonella spp., Escherichia coli, Estafilococos coagulase positivo, entre outras análises.
Nas amostras coletadas para atendimento PACPOA também são realizadas análises para pesquisas de indícios de fraude, como por exemplo; desglaciamento, polifosfatos, análise de DNA para identificação de espécies e etc.
Já entre os regulamentos da ANVISA de maior importância para pescado, Cioffi chama especial atenção para RDC Nº 331/2019 e IN60/2019, que dispõem sobre os padrões microbiológicos de alimentos e estabelecem as listas de padrões microbiológicos para alimentos prontos para oferta ao consumidor, respectivamente. “No que tange às determinações, observamos que o escopo microbiológico do referido regulamento ANVISA está harmonizado com o PAC POA MAPA”, observou.

Como elas são feitas?
As análises são realizadas de acordo com a metodologia e/ou técnica prevista para a respectiva determinação e matriz da amostra. “É importante que o laboratório tenha um sistema de gestão de qualidade (SGQ) acreditado pela CGCRE do INMETRO de acordo com a norma ABNT NBR ISO/IEC 17025:2017”, falou a gerente.
A ISO 17025 trata-se de uma norma que rege os sistemas de gestão de qualidade em laboratório, sendo feita exclusivamente para laboratórios de calibração, ensaio e amostragem a fim de garantir não apenas o cumprimento das obrigações legais, mas também a precisão e a qualidade nos resultados obtidos.
Além disso, Cioffi explica que o laboratório deve ter equipe qualificada e com experiência em análises de pescado, garantindo dessa forma, a correta execução das análises e a devida análise crítica dos resultados obtidos.
Quais laboratórios podem fazê-las?
A coleta de amostras oficiais é realizada por servidores públicos que atuam na inspeção federal e as análises oficiais são realizadas pelos Laboratórios Federais de Defesa Agropecuária (LFDAs), próprios do Mapa ou podem ser realizadas pelos laboratórios credenciados na Rede Nacional de Laboratórios Agropecuários, ambos estão vinculados à Coordenação Geral de Laboratórios Agropecuários (CGAL).
A lista de laboratórios pode ser consultada por área de atuação e/ou estado, no site do Mapa na área de laboratórios.
“Além dos procedimentos oficiais, existe a realização de análises para autocontrole, nesse caso é importante se atentar ao fato de que laboratório escolhido utilize as metodologias analíticas oficiais reconhecidas pelo Mapa, conforme Manual de Métodos Oficiais para Análise de Alimentos de Origem Animal- 2º edição (Brasil, 2019c)”, completou a gerente.
TUV SUD SFDK
O Laboratório TUV SUD SFDK faz parte do Grupo TUV SUD que é uma empresa centenária, fundada em 1866; são mais de 150 anos trabalhando com soluções de segurança, proteção e sustentabilidade através de um portfólio abrangente de serviços de teste, certificação e auditorias. Com mais de 25000 funcionários estão presentes em todos os continentes em mais de 1000 localidades.
, ANVISA, Laboratório TUV SUD SFDK, Mapa, Márcia Cioffi, produto de pescado

.jpg)




